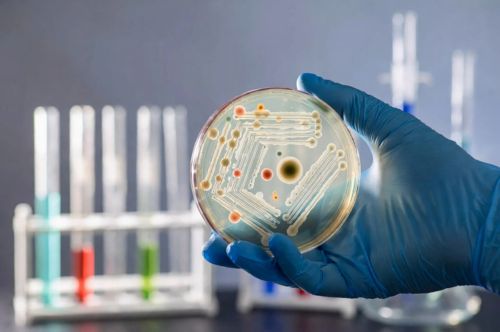
Антибиотикорезистентность: гонка на выживание

Блог

Что необходимо и достаточно делать в быту, чтобы уменьшить вероятность заражения COVID-19?
В статье мы подробно расскажем об этом по пунктам.

Как не переедать из-за стресса? Советы диетологов
Эпидемия в разгаре. Долгое сидение на карантине, проблемы с работой, тревога за будущее, стресс от уменьшения привычного общения с друзьями, беспокойство за старших родственников, необходимость…

Euromed Clinic: сделайте рентген на дому и вызовите врачей-специалистов
Услуга вызова травматолога-ортопеда на дом с рентген-диагностикой временно НЕДОСТУПНА

Обращение директора по коммерческим ресурсам Euromed Group
«Дорогие пациенты, хочу обратиться к вам и разъяснить, что именно подразумевает постановление Главного санитарного врача по городу Санкт-Петербургу № 3 от 23.03.2020 и Постановления Правительства…

Что такое нейропластичность?
Коротко: нейропластичность — свойство мозга, благодаря которому свойства нейронов и нейронные сети могут изменяться под воздействием нового опыта, в том числе — восстанавливать или формировать…

Правда и мифы об иммунитете
Разговоры о том, как не болеть простудными заболеваниями, «укреплять» и «поддерживать» иммунитет — неизбежны в любое время года. Предлагаем вместе разобраться: что правда, а что…

До 120 — не предел?
Жить, как библейские старцы, — по шестьсот и тысячу лет? Или, если это невозможно, хотя бы оставаться здоровым, бодрым и жизнелюбивым до ста двадцати? Долгожительство (а…

Мы — Euromed
По поводу 20-летия компания мы сняли фильм с основателями и сотрудниками клиники, которые лучше всех расскажут о том, почему Euromed – не просто клиника, а…

Диагностика будущего
Когда думаешь о медицинских инновациях, первой на ум приходит именно диагностика. Сначала всё, что было у врача, —это его органы восприятия (он мог обследовать, выслушивать,…

7 методов современной офтальмологии, улучшающих зрение человека!
Офтальмология — одна из благороднейших отраслей медицины. Возвращать человеку зрение, давать ему возможность видеть мир можно разными способами.
Антибиотикорезистентность: гонка на выживание
Были времена, когда эпидемии чумы, чёрной оспы, холеры могли беспрепятственно выкосить целый город, когда практически все дети болели корью и скарлатиной, а многие — и…

Сколько спать, чтобы высыпаться? И еще 21 вопрос сомнологу
Сон — самый главный фактор, влияющий на наше здоровье. Не «один из», а именно самый. Поэтому мы и начали нашу серию статей с него.

Ведущий специалист-оториноларинголог из Европы в Euromed Clinic!
9 сентября в нашей клинике будет вести прием профессор, доктор медицинских наук, специалист по лечению заболеваний ЛОР-органов — Юрген Штрутц.

Будущее — за имплантацией!
Сделать маленькую операцию и вшить себе футуристический чип? Стать киборгом? Брр, страшно! Мешает естественный психологический барьер, из-за которого трудно решиться на включение в свое…

Пульс времени: искусственный интеллект в кардиологии
Искусственный интеллект в медицине? Машина вместо врача? Это может показаться чем-то неуютным и дискомфортным, ведь нам хочется, чтобы нас лечил человек, «которому можно посмотреть…

Пациент из Кирибати, или как важно проверить всё!
Этот кейс о том, как важно внимательно проводить дифференциальную диагностику, не пренебрегая исследованиями, которые могут на первый взгляд показаться неочевидными. В частности, и эндоскопией.

Простые вещи: носимые гаджеты и медицина
Бум носимых гаджетов продолжается уже пять лет — в том числе и в медицине. Маленькие и очень маленькие устройства позволяют измерять самые разные показатели,…

Смотреть — не значит видеть!
Зрение для человека представляет величайшую ценность, и знать о том, как сохранить его или улучшить его, должен каждый.



